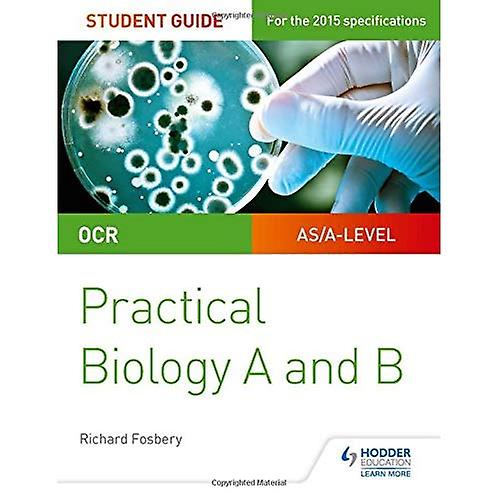
OCR A-level Biology Student Guide: Biología práctica

OCR A-level Biology Student Guide: Practical Biology
+ 3,49 € Envío
OCR A-level Biology Student Guide: Practical Biology
- Marca: Unbranded
OCR A-level Biology Student Guide: Practical Biology
- Marca: Unbranded
Política de devoluciones de 14 días
Política de devoluciones de 14 días
Métodos de pago:
Descripción
OCR A-level Biology Student Guide: Practical Biology
- Marca: Unbranded
- Categoría: Ciencia ficción y fantasía
-
Idioma: Inglés
-
Fecha de publicación: 28/04/2017
-
Autor: Fosbery, Richard
-
Longitud: Páginas: 104
-
Editor / Marca: Educación de Hodder
-
Tamaño: 24,5 x 19 x 0,8 centímetros (0,2
-
Formato: Libro en rústica
- Nº de Fruugo : 28680785-60988884
- ISBN: 9781471885617
Entrega y devolución
Enviado en un plazo de 7 días
-
STANDARD: 3,49 € - Entrega entre mié 21 enero 2026–vie 30 enero 2026
Envío desde Reino Unido.
Hacemos todo lo posible para asegurarnos de que se le entreguen los productos que pida en su totalidad y de acuerdo con sus especificaciones. Sin embargo, si recibe un pedido incompleto o artículos diferentes a los que pidió, o hay alguna otra razón por la que no está satisfecho con el pedido, puede devolver el mismo o cualquier producto incluido en él y obtener un reembolso completo por los artículos. Vea la política de devolución completa